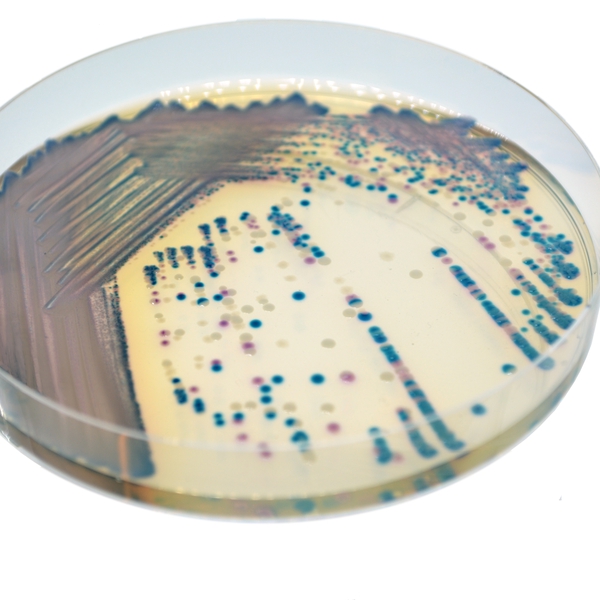
CHROMagar™ COL-APSE

Hình thái khuẩn lạc

COL-R E. coli
Hồng đậm đến đỏ

COL-R Klebsiella, Enterobacter, Citrobacter
Xanh kim loại

COL-R Pseudomonas
Màu kem trong suốt đến xanh lá cây

COL-R Acinetobacter
Màu kem, mờ đục
Hiệu năng
Hiệu năng
Polymyxin E (colistin) và B ngày càng được sử dụng nhiều trong điều trị các nhiễm khuẩn đa kháng thuốc. Kháng Polymyxin, mặc dù là kháng tự nhiên ở vi khuẩn Gram dương và một số loài Gram âm (Proteus, Morganella, Serratia), hiện đang là vấn đề trong một số tác nhân khác (Acinetobacter baumannii, Pseudomonas aeruginosa, Escherichia coli, Salmonella enterica, Klebsiella pneumoniae).*
Kháng thuốc xuất hiện do đột biến/chèn vào các gen liên quan đến sinh tổng hợp LPS (lpx, pmrA/B, mgrB, phoP/Q) và/hoặc sự tiếp nhận phosphoethanolamine transferases (PEtN). Đáng lo ngại là sự xuất hiện gần đây của PEtN mã hóa plasmid, MCR-1, hiện đã được tìm thấy trên toàn thế giới trong nhiều loại vi khuẩn từ động vật, người và môi trường.*
CHROMagar™ COL-APSE là một môi trường chromogen nhạy và đặc hiệu cho sự phát triển của tác nhân kháng Colistin với giới hạn phát hiện thấp là 10 CFU/mL. Môi trường chromogenic mới này có thể hữu ích như một môi trường phân lập chính trong giám sát và thu hồi vi khuẩn kháng Colistin từ các mẫu phức tạp từ người, thú y và môi trường, đặc biệt là những mẫu có cơ chế kháng polymyxin qua plasmid MCR-1 hoặc mới.*
* Môi trường Nuôi cấy Chromogenic Mới (CHROMagar™ COL-APSE) để Phân lập và Phân biệt Tác nhân Kháng Colistin Gram âm. Muhd Haziq F Abdul Momin, David W Wareham. ECCMID 2017.
Mục đích sử dụng :
CHROMagar™ COL-APSE là môi trường nuôi cấy chromogen chọn lọc và phân biệt, dùng để phát hiện định tính trực tiếp tình trạng mang mầm bệnh Gram âm kháng colistin (COL-R) để hỗ trợ phòng ngừa và kiểm soát COL-R trong các cơ sở y tế. Xét nghiệm được thực hiện với mẫu gạc trực tràng, gạc vùng perine, và phân từ bệnh nhân để sàng lọc tình trạng mang mầm bệnh COL-R. Kết quả có thể được diễn giải sau 18-24 giờ ủ hiếu khí ở 35-37 °C.
Môi trường này cũng có thể được sử dụng như chỉ báo cảnh báo sớm cho xét nghiệm chẩn đoán nhiễm khuẩn để báo hiệu có thể có mặt vi khuẩn COL-R. Việc sử dụng này không thay thế quy trình của tổ chức.
CHROMagar™ COL-APSE không nhằm chẩn đoán nhiễm COL-R hay hướng dẫn hoặc theo dõi điều trị nhiễm khuẩn. Việc không có sự phát triển hay thiếu khuẩn lạc trên CHROMagar™ COL-APSE không loại trừ sự hiện diện của COL-R. Cần xác định thêm, thử nghiệm độ nhạy, và định danh dịch tễ học trên các khuẩn lạc nghi ngờ.
CHROMagar™ COL-APSE cũng có thể được sử dụng trong phát hiện COL-R trong phân tích sản phẩm thực phẩm cho người tiêu dùng, thức ăn gia súc, trong chăn nuôi và trong các mẫu môi trường.
1. Sự phân biệt màu sắc của khuẩn lạc với kháng colistin thu nhận được phân biệt giữa E. coli, coliforms, Pseudomonas và Acinetobacter.
2. Giới hạn phát hiện ấn tượng:
10 CFU/mL.

Thành phần

Tài liệu kỹ thuật
Công bố khoa học
2019
Assessment of two selective agar media to isolate colistin-resistant bovine Escherichia coli: Correlation with minimal inhibitory concentration and presence of mcr genes
📄 Publication2019
Prevalence of Genes involved in Colistin resistance in Acinetobacter baumannii: First Report from Iraq
📄 Publication2018
Antimicrobial Resistance Surveillance of Human Faecal Samples reveals a High Carriage Rate of E. coli MCR-1 in Brunei Darussalam
📄 Publication2018
Wide dissemination of colistin-resistant Escherichia coli with the mobile resistance gene mcr in healthy residents in Vietnam
📄 Publication2017
A Novel Chromogenic Culture Media (CHROMagar™ COL-APSE) for the Isolation and Differentiation of Colistin Resistant Gram-negative Pathogens
📄 Publication2017
CHROMagar COL-APSE: a selective bacterial culture medium for the isolation and differentiation of colistin-resistant Gram- negative pathogens
📄 Publication

Xem thêm